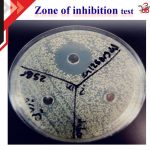
مضاد للبکتریا لتحديد قطر منطقة التثبيط

اختبار مضاد للبكتيريا لتحديد MIC و MBC
$17.00
اختبار مضاد للبكتيريا لتحديد MIC و MBC
يعد اختبار MIC و MBC المضاد للبكتيريا طريقة لقياس التأثيرات المضادة للبكتيريا للمركبات والتركيبات وهو أحد أهم تحليلات علم الأحياء الدقيقة والأكثر استخدامًا. معنى MIC هو تركيز مضاد للجراثيم يمكن أن يثبط نمو البكتيريا في بيئة معملية ، ومعنى MBC هو أقل تركيز للعقار الذي يدمر البكتيريا. في التحليل لتحديد MIC و MBC ، سيتم الإبلاغ عن مقدارهما إذا كان أقل من 1 مجم / مل.
كلما كانت هذه القيم أقل في تحليل المضاد الحيوي ، كلما كانت القوة المضادة للبكتيريا للمركب أقوى. هذا الاختبار هو مكمل للاختبار لتحديدZone of inhibition . ومع ذلك ، فهي طريقة أكثر ملاءمة بشكل عام للجسيمات غير القابلة للذوبان مثل الجسيمات النانوية. ازدادت أهمية اختبارات MIC و MBC اليوم بسبب زيادة مقاومة البكتيريا للأدوية. في المختبر الدکتور بنیامین ، يتم إجراء هذا الاختبار لمجموعة واسعة من البكتيريا موجبة وسالبة الجرام عالية الجودة.
حول الإختبار
اختبار مضاد للبكتيريا لتحديد MIC و MBC
يعد قياس تأثير المواد على نمو البكتيريا من أهم اختبارات علم الأحياء الدقيقة. تسمى تأثيرات، وتثبيط نمو البكتيريا ،التأثيرات المضادة للبكتيريا ، والتي تظهر بشكل رئيسي في أدوية المضادات الحيوية. تستخدم اختبارات المضادات الحيوية بشكل روتيني في مختبرات علم الأحياء الدقيقة للتحقق من فعالية المضادات الحيوية لاختيار المضاد الحيوي الأكثر فعالية للبكتيريا.
تحليل المضاد الحيوي أو المضاد للبكتيريا هو دراسة فعالية المضادات الحيوية أو غيرها من المركبات المضادة للميكروبات لمنع نمو البكتيريا. يمكن دراسة هذه القدرة باستخدام طرق التخفيف في الأنابيب أو زراعة الكائنات الحية الدقيقة في الأطباق. تعتمد أساسيات مضادات البكتيريا على مصطلحين في ميكروبيولوجية:
(Minimum Inihibitory Concentration (MIC
(Minimum Bactericidal Concentration (MBC
معنى MIC هو تركيز مضاد للبکتریا يمكن أن يثبط نمو البكتيريا في بيئة معملية ، ومعنى MBC هو أقل تركيز للعقار الذي يدمر البكتيريا.

المراجعات
مسح الفلاترلا توجد مراجعات بعد.